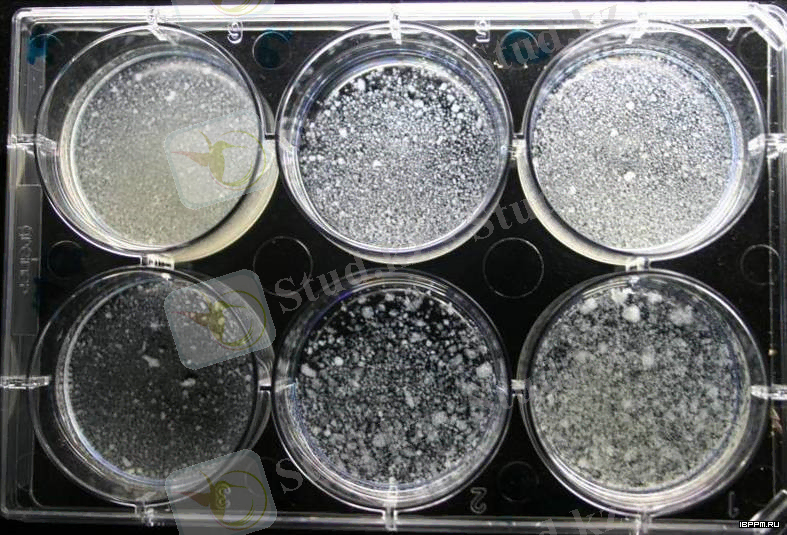
http://ibppm.ru/uploads/posts/2015-04/1429452492_agregaciya-kletok.jpg

Клетка суспензиясының сұйық қоректік ортада өсірілуі: мерзімді, үзіліссіз және ағынды жүйелер


ҚАЗАҚСТАН РЕСПУБЛИКАСЫНЫҢ
БІЛІМ ЖӘНЕ ҒЫЛЫМ МИНИСТІРЛІГІ
СӨЖ
Тақырыбы: Клетка суспензиясының культурасы
Тексерген:
Орындаған:
Топ:
Семей қаласы
2016
Жоспар:
- Клеткаларды сұйық қоректік ортада өсіру
- Мерзімді өсіру
- Өсіру циклі
- Ағынды жабық жүйе
- Ағынды ашық жүйе
- Ағынды-ағынсыз жүйе
Клеткаларды сұйық қоректік ортада өсірудің негізгі екі әдісі болады: 1) мерзімді өсіру; 2) үзіліссіз өсіру.
Бұлар әр түрлі әдістер болғанымен олардың түп мақсаты бір. Ол мақсат - клеткалар биомассасын неғұрлым көбейтіп, олар түзетін пайдалы заттарды соғұрлым мол өндіру. Ал бұл әдістердің айырмашылықтарына келер болсақ, олар қоректік ортаның сапасын және клеткалардың өсуін реттеуге байланысты. Енді осы әдістерге жеке-жеке тоқталайық.
Мерзімді өсіру деп бұл әдістің аталу себебі, суспензиядағы клеткаларды өсіру процесі белгілі бір уақыт ішінде жүргізіледі және де бұл кезде бастапқы құйылған қоректік орта жаңартылмай, өз нәрі сарқылғанша пайдаланылады. Ал енді бұл мерзім қалай белгіленеді, соған келейік. Ол клеткалардың өсу зандылықтарына байланысты. Бұл мәселе толығымен кейінірек баяндалады. Қазірше айта кететін өсіру циклі туралы мәлімет.
Өсіру циклі -инокулюмды қорекгік ортаға қосқаннан бастап, келесі жас ортаға ауыстырғанға дейінгі мерзім. Еске салсақ, инокулюм дегеніміз қарқынды өсу қабілеті бар суспензияның бөлініп алынған шағын көлемі. Инокулюмдағы клеткалар жаңа сұйық ортаға салынған соң, оның құрамындағы қоректік заттарды өз бойына сіңіріп, бөліну және созылу арқылы өсе бастайды. Біртіндеп олардың өсу қарқындылығы арта түседі. Соған байланысты қоректік ортаның нәрі азая береді. Сол себептен клеткалардың өсу қарқындылығы да бәсеңдейді, тіпті тежеледі де. Осы кезде суспензияны өсіру процесін тоқтатып, клетка биомассасын жинақтап бөліп алуға болады. Осымен өсіру циклі аяқталады.
Ал клеткаларды қайтадан өсіру үшін инокулюм жаңа қоректік ортаға көшіріледі де өсіру циклі тағы да басталады. Міне, осылай оқтын-оқтын қайталанып, белгілі бір уақыт бойы клеткалар суспензиясын өсіруді мерзімді өсіру дейміз. Бұл әдіс қорландырып өсіру деп те аталады. Бұл атау клеткалардың суспензияда өсуі нәтижесінде биомасса қоры жинақталуына байланысты берілген. Мерзімді немесе қорландырып өсіру кезінде клеткалардың өсу қарқындылығын және қоректік ортаның сапасын реттеу қиынға соғады. Сондықтан өндірістік жағдайда басқа әдіс - үзіліссіз өсіру әдісі кеңінен пайдаланылады.
Үіліссіз өсіру деп бұл әдістің аталу себебі, суспензиадағы клеткаларды өсіру процесі үздіксіз жүргізіледі және де қоректік орта ылғи жаңартылып тұрады. Бұл өте тиімді әдіс. Мол өнім алу бірнеше жолмен қамтамасыз етіледі: 1) клеткалардың көбі өсу процесінің экспоненциалды фазасында бола алады; 2) биомассаны өндіріске ыңғайлы қай кезде болса да суспензиядан бөліп алуға болады; 3) сұйық қоректік орта ағынды боп құйылып тұратындықтан, оның сапасы төмендемейді, нәрі сарқылмайды. Үзіліссіз өсірудің мынадай жүйелері бар: 1) ағынды жабық; 2) ағынды ашық; 3) ағынды-ағынсыз.
Ағынды жабық жүйе. Клеткалық суспензияны өсіргенде сұйық қоректік орта ағынды боп құйылып, аумалы-төкпелі алмастырылып, жаңартылып тұрады. Сұйық ортаның жүйеге (ферментер аппаратқа) кіріп құйылу қарқыны мен оның төгіліп сыртқа шығу қарқыны бірдей болу керек. Бұл перистальтикалық насостың қызметін реттеу арқылы іске асырылады. Сонда клеткалар суспензиясы өсірілетін жүйеде қоректік ортаның мөлшері де, сапасы да бір қалыпты болып сақталады және де оның нәрі сарқылмайды. Сондықтан, клеткалардың өсуінің бәсендемей, тежелмей жүруіне қолайлы жағдай туады. Қоректік ортаның пайдаланылған бөлігі сыртқа сүзгіш түтік арқылы шығарылады. Сонда суспензиядағы клеткалар жүйенің ішінде жабыңқы жағдайда қалып, өсуін жалғастыра береді. Ағынды жабық жүйе деп аталуы осы ерекшеліктерге байланысты.
Ағынды ашық жүйе. Суспензиядағы клеткаларды өсірудің жалпы принципі жоғарыда айтылғандай, бірақ күрделі ерекшелігі де бар. Егер ағынды жабық жүйеде сыртқа өсіп жаткан клеткалар емес, тек қана сүзгіштен өткен пайдаланылған қоректік ортаның біраз бөлігі шығарылып тұрса, ағынды ашық жүйеде сыртқа клеткалар суспензиясының бөлігі шығарылады. Бұл тәсілде сүзгіш түтік қолданылмайды, сондықтан қоректік ортамен қоса клеткалар да төгіліп шығады. Бөлініп алынған клеткалардың мөлшері (саны немесе биомассасы) жүйе ішінде қалған клеткалардың өсу қарқынына сәйкес болу керек. Сыртқа шығарылып алынған клеткалардың орнын жаңадан пайда болып өскен басқа клеткалар толтырады. Ағынды ашық жүйе деп аталудың себебі, клеткалар биомассасы еркін ағып шығып алына береді.

- Іс жүргізу
- Автоматтандыру, Техника
- Алғашқы әскери дайындық
- Астрономия
- Ауыл шаруашылығы
- Банк ісі
- Бизнесті бағалау
- Биология
- Бухгалтерлік іс
- Валеология
- Ветеринария
- География
- Геология, Геофизика, Геодезия
- Дін
- Ет, сүт, шарап өнімдері
- Жалпы тарих
- Жер кадастрі, Жылжымайтын мүлік
- Журналистика
- Информатика
- Кеден ісі
- Маркетинг
- Математика, Геометрия
- Медицина
- Мемлекеттік басқару
- Менеджмент
- Мұнай, Газ
- Мұрағат ісі
- Мәдениеттану
- ОБЖ (Основы безопасности жизнедеятельности)
- Педагогика
- Полиграфия
- Психология
- Салық
- Саясаттану
- Сақтандыру
- Сертификаттау, стандарттау
- Социология, Демография
- Спорт
- Статистика
- Тілтану, Филология
- Тарихи тұлғалар
- Тау-кен ісі
- Транспорт
- Туризм
- Физика
- Философия
- Халықаралық қатынастар
- Химия
- Экология, Қоршаған ортаны қорғау
- Экономика
- Экономикалық география
- Электротехника
- Қазақстан тарихы
- Қаржы
- Құрылыс
- Құқық, Криминалистика
- Әдебиет
- Өнер, музыка
- Өнеркәсіп, Өндіріс
Қазақ тілінде жазылған рефераттар, курстық жұмыстар, дипломдық жұмыстар бойынша біздің қор #1 болып табылады.



Ақпарат
Қосымша
Email: info@stud.kz